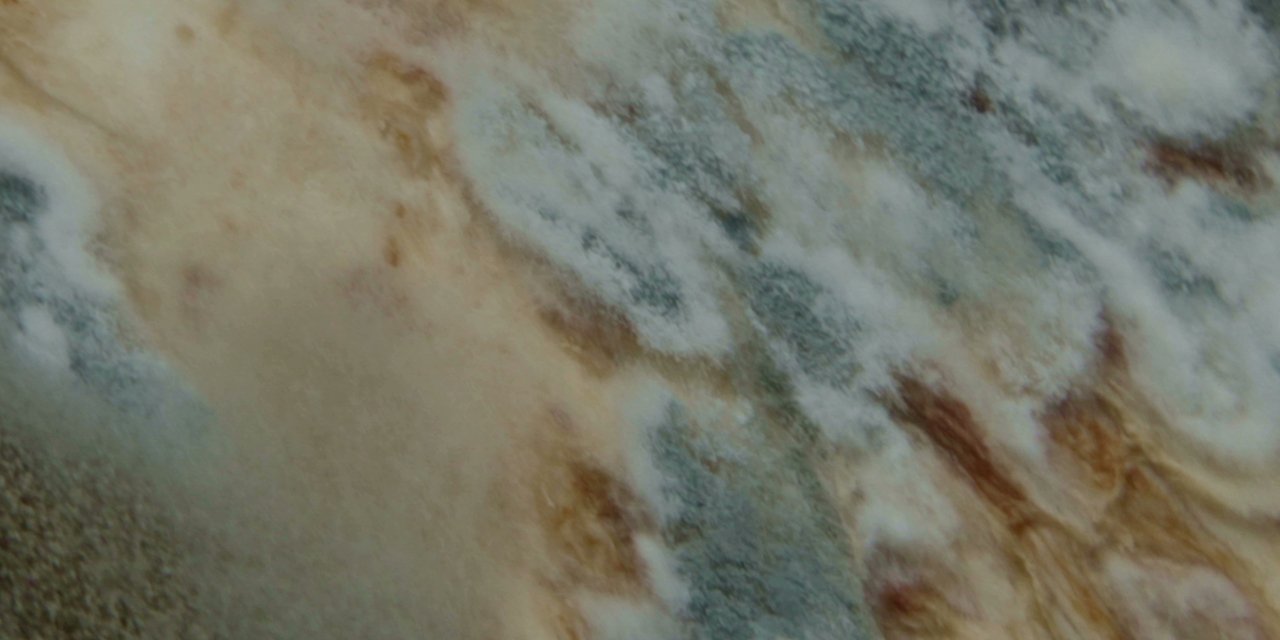

Tour&Bravö Hits
April 2019

on Tour in Linz
Linz: Moviemento Mai 2019
Kennen Sie … Raphaela Schmid?
Oder Lisa Maria Bickel? Oder Max Hammel? Nein? Sollten Sie aber. Denn diese kreativen Köpfe aus Oberösterreich präsentieren am 21. Mai ihre neuesten Filme und zeigen, was der junge heimische Film zu bieten hat.
Cinema Next ist wieder im Moviemento zu Gast! Halbjährlich – immer im Mai und Oktober – und zum nun 16. Mal präsentiert die Initiative auf einer Kurzfilmtour in mehreren Städten junges Kino aus Österreich in außergewöhnlichen Programmen. Das Programm in Linz gibt wieder einen spannenden Einblick ins junge Filmschaffen aus Oberösterreich: Raphaela Schmids Kurzfilm ENE MENE verhandelt auf schöne Weise Abschiedsgefühle innerhalb einer Familie. Sie wurde für ihren Film auf der Diagonale in Graz mit dem Kurzspielfilmpreis ausgezeichnet. In Max Hammels märchenhaftem Kurzfilm l'Oasis treiben sich zwei Freunde in einem Garten Schritt für Schritt in den Wahnsinn. Die junge Frau in Lisa Maria Bickels Kurzfilm Sehr lauwarm durchlebt hingegen Gefühle der leiseren Art: im sommerlichen Linz driftet sie ohne Ziel durch den Tag. Das "Oberösterreich-Programm" wird angereichert mit neuen Filmen von weiteren heimischen Filmtalenten, vom amüsanten FKK-Badefilm frisch des jungen Regietalents Tim Oppermann bis zum bissig-reflexiven Dialog unter Vampiren in einer neuen Arbeit von Kurdwin Ayub. Sollten Sie alle kennen, sollten Sie alles sehen!
Facebook-Veranstaltungsseite Tour-Programmfolder Kartenreservierung Moviemento

Nach Oben